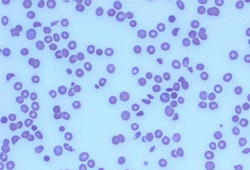

Images and videos
Images
Hemolytic uremic syndrome
Peripheral smear with numerous fragmented erythrocytes
From the personal collection of Dr A. Zimrin; used with permission
See this image in context in the following section/s:
Use of this content is subject to our disclaimer